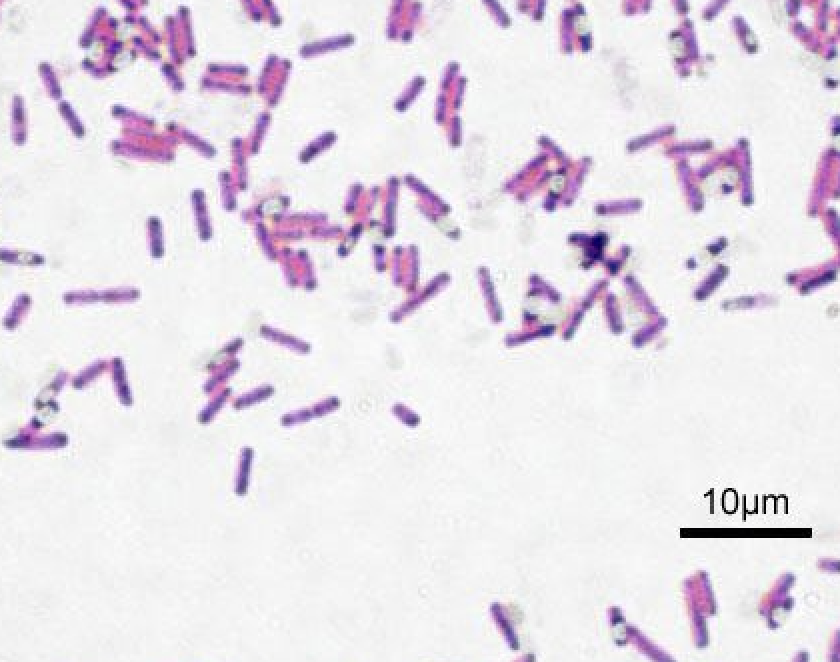

Firmicutes
Firmicutes is a one of the major phyla in the human gut with many beneficial bacteria but some problematic bacteria at high levels.
Taxonomic Level: Phlyum
Properties: Mostly gram-positive, Spore forming
Additional Information: Firmicutes is known to have the highest abundance of gut bacteria, but too much is unsafe for a number of reasons. Firmicutes is a Sulphate Reducing Bacteria- which produces hydrogen sulfide; hydrogen sulfide is toxic outside of healthy levels and can cause colonocyte apoptosis, degradation of mucous, and can inhibit butyrate production (please see the functional analysis section of your report to learn more about hydrogen sulfide). Butyrate is a short chain fatty acid which has many beneficial health implications, including protection against inflammatory bowel disease, diabetes, obesity, and cancer (please see the functional analysis section of your report to learn more about butyrate). There are certain species of Firmicutes with benefits to your metabolism, such as Faecalibacterium prausnitzii, which reduces chronic inflammation. However, high levels of other species of Firmicutes have been seen in patients with obesity, type II diabetes, and irritable bowel syndrome. Eating foods rich in fiber has been seen to increase Firmicutes abundance.